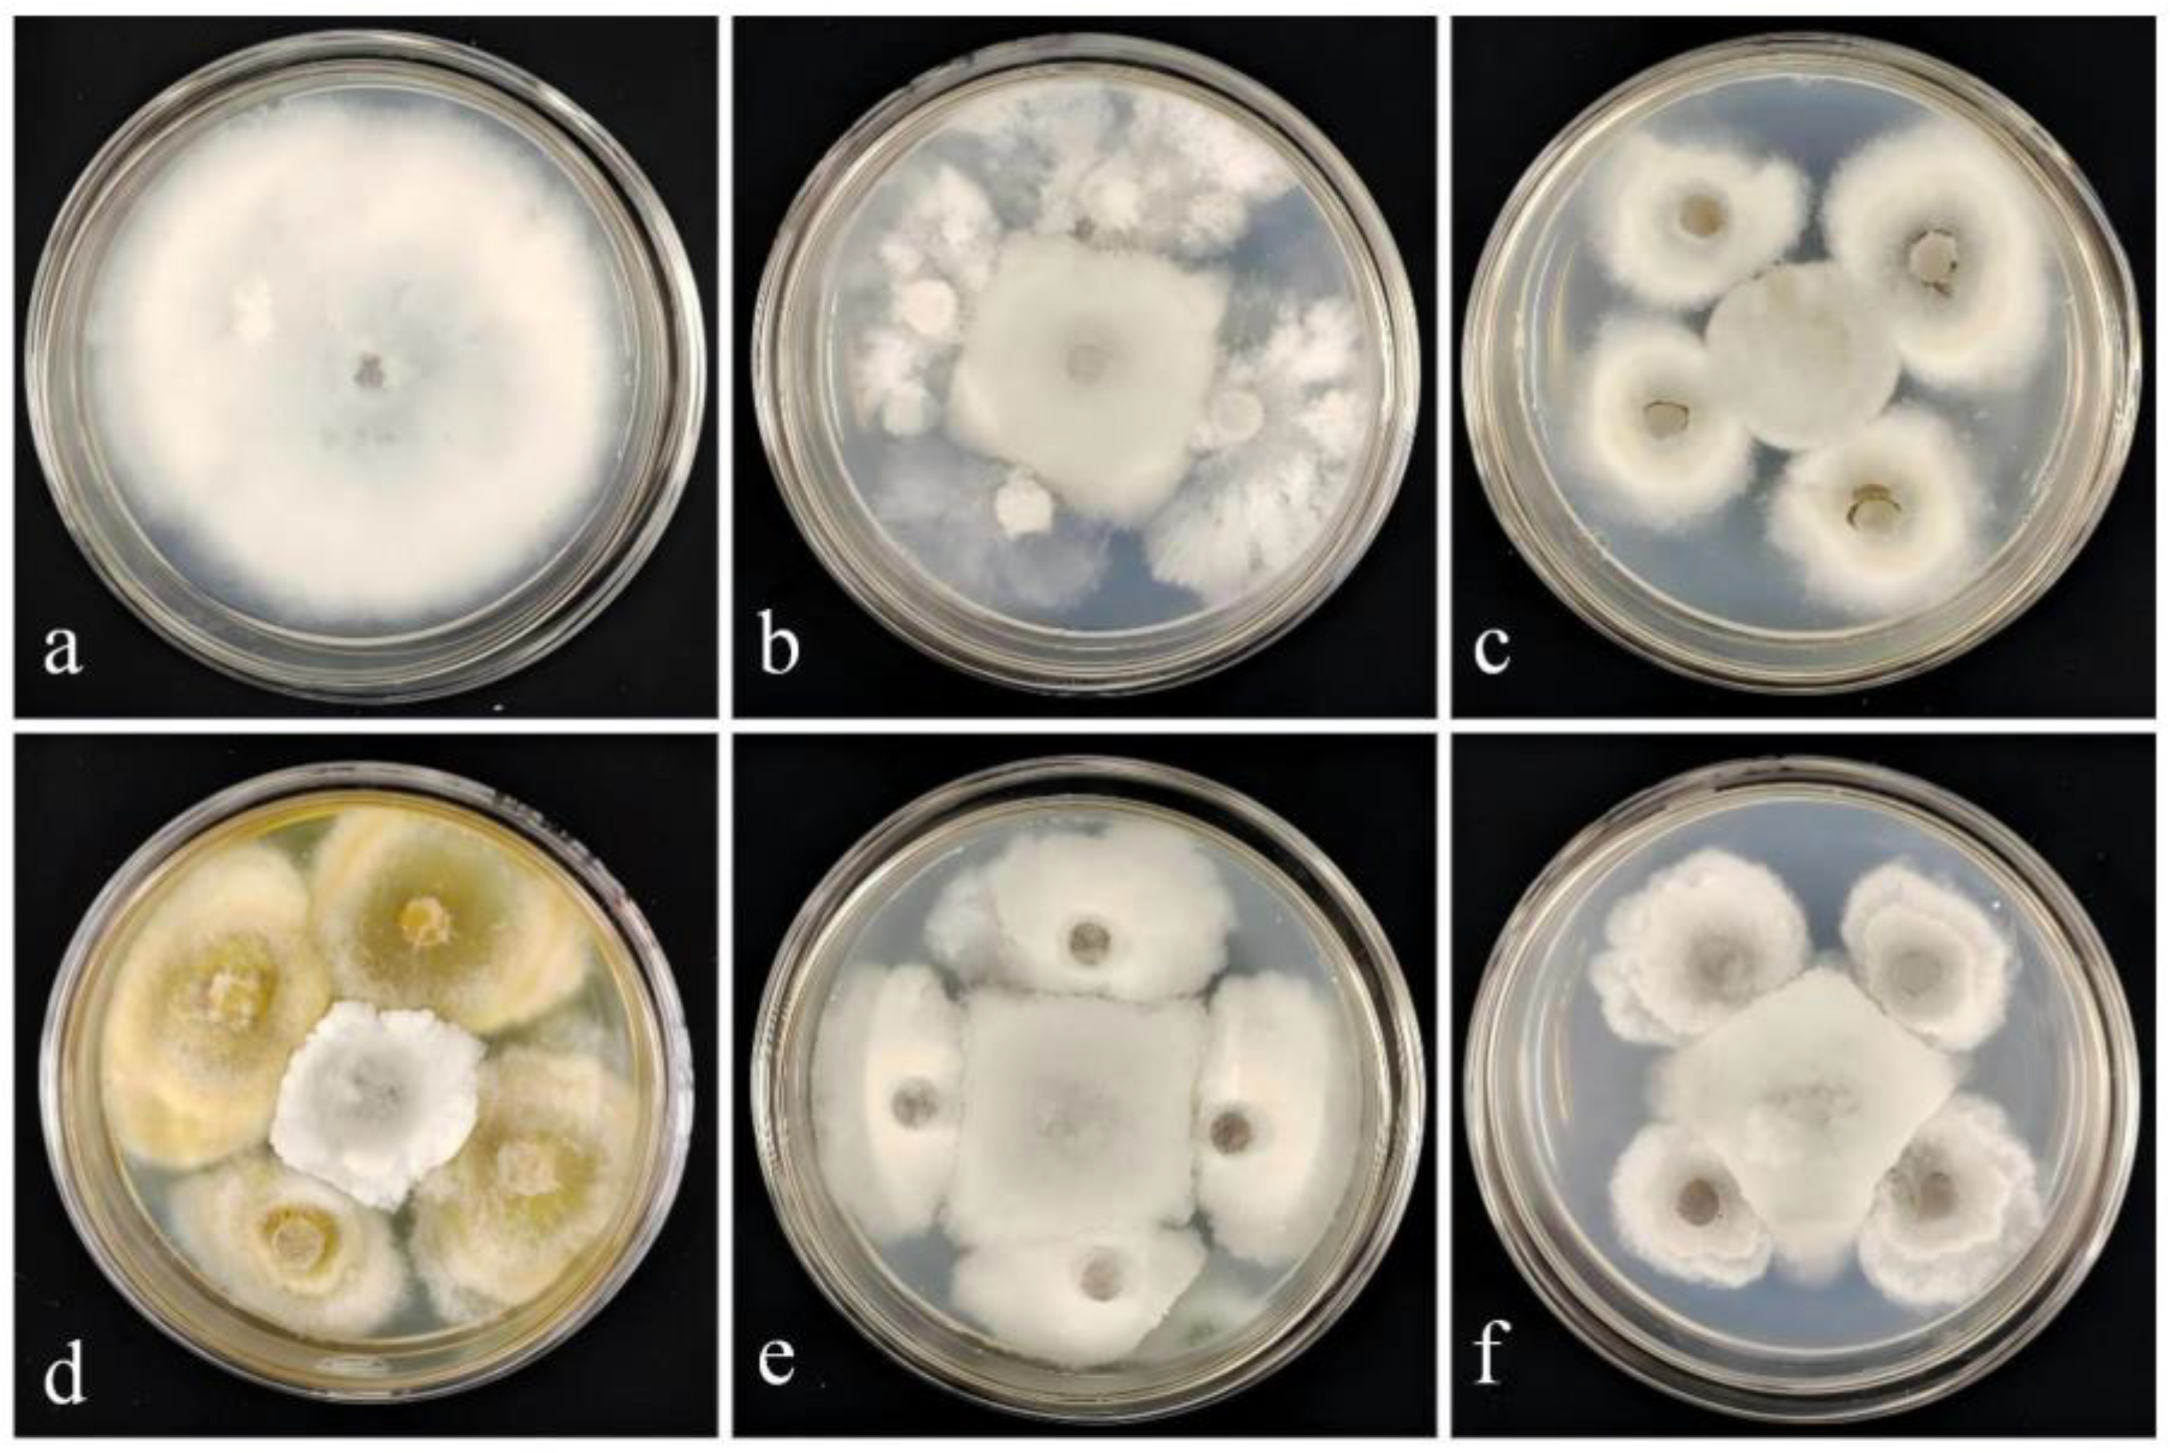
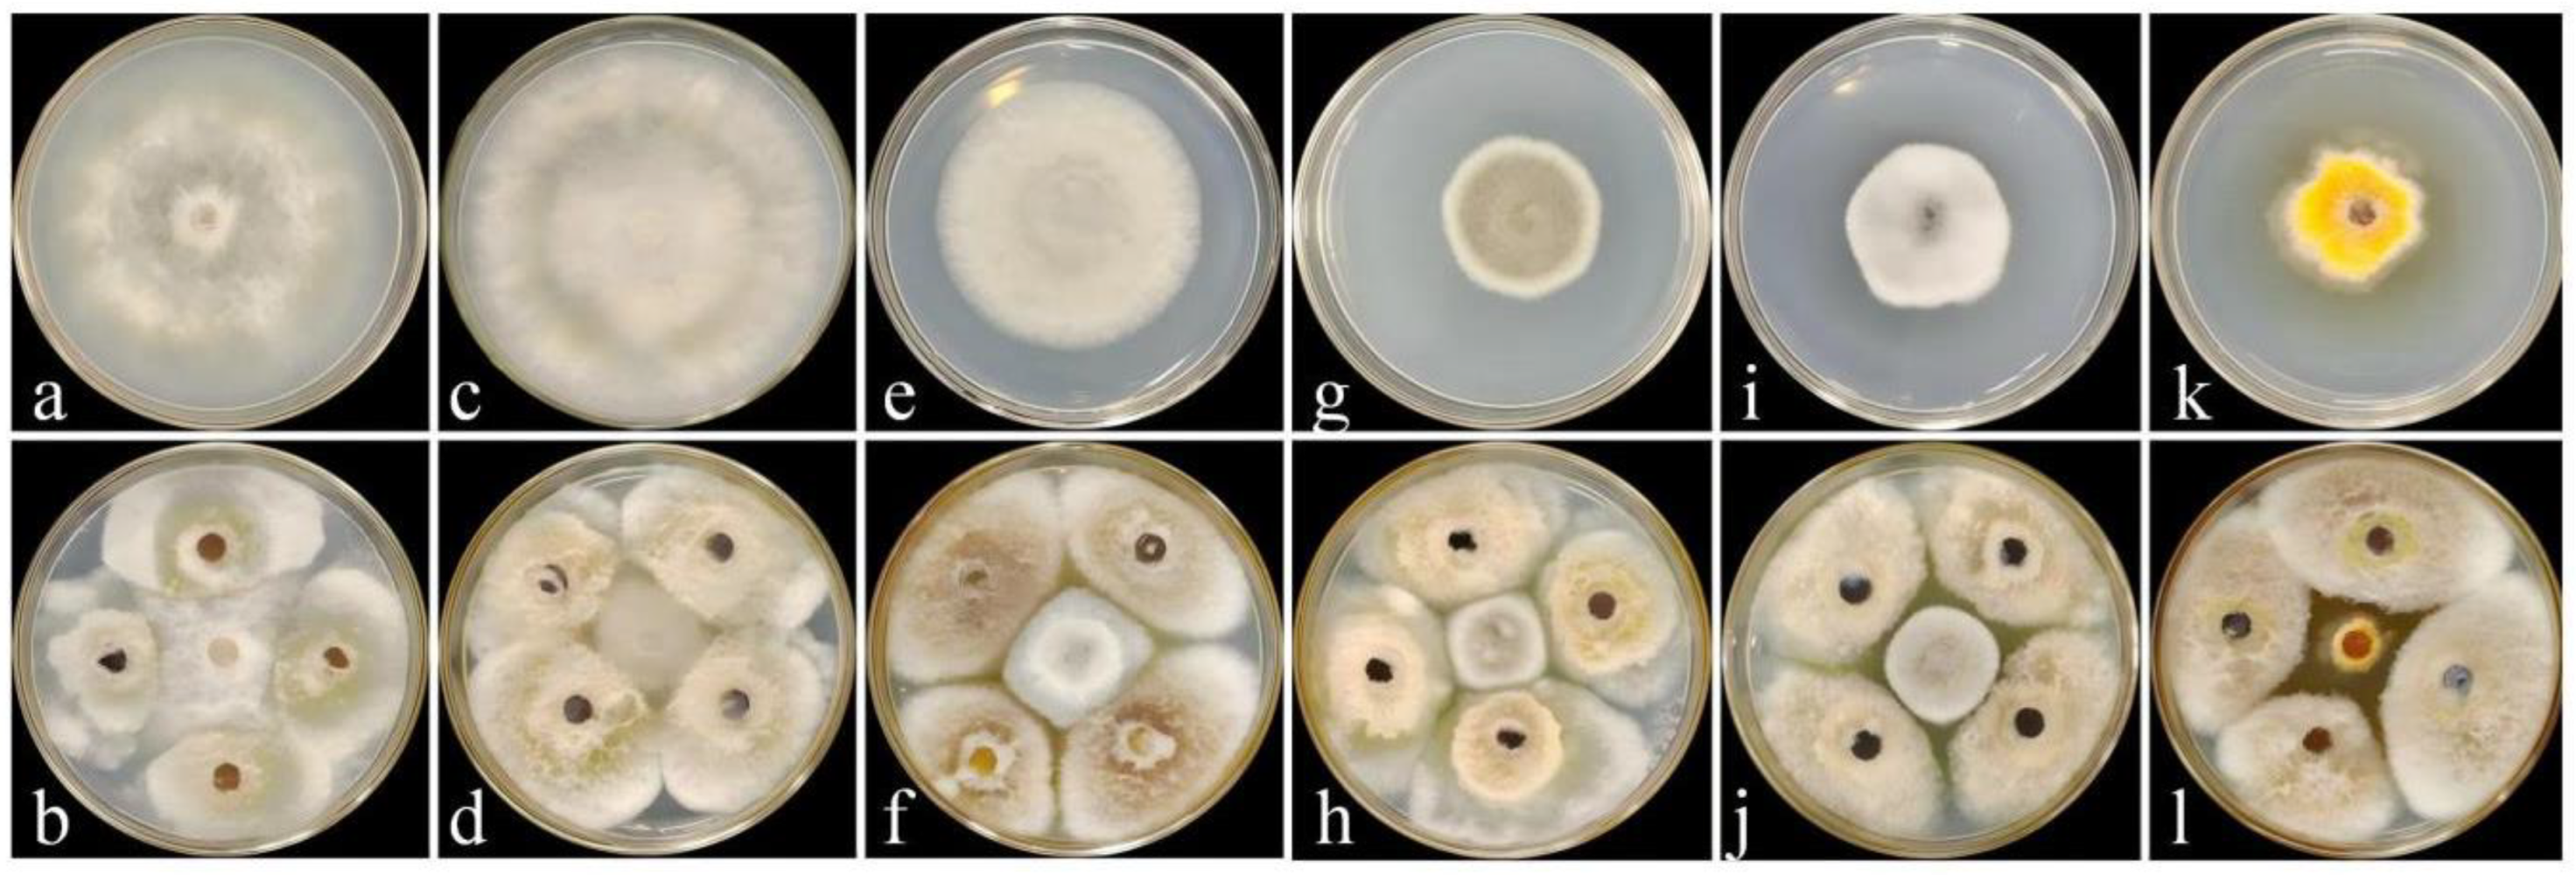

Identification of the Antagonistic Fungus Diaporthe phoenicicola Against Rhododendron Brown Spot Disease and Its Disease Control and Plant Growth-Promoting Efficacy
Abstract
1. Introduction
2. Materials and Methods
2.1. Plant Materials Tested
2.2. Test Strains and Culture Media
2.3. Screening of Biocontrol Fungi and Determination of Their Broad-Spectrum Antifungal Activity
2.4. Identification and Phylogenetic Tree Analysis of Biocontrol Fungi
2.5. Determination of Extracellular Hydrolases in Biocontrol Fungi
2.6. Biocontrol Efficacy of Biocontrol Fungi
2.7. Study on Growth-Promoting Characteristics of Biocontrol Fungi
2.7.1. Determination of Growth-Promoting Ability of Biocontrol Fungi
2.7.2. Pot Experiment on Growth Promotion by Biocontrol Fungi
2.8. Effect of Biocontrol Fungi on Defense Enzyme Activities in Rhododendron Seedlings
2.9. Statistical Analysis of Data
3. Results and Analysis
3.1. Isolation and Screening of Biocontrol Fungi
3.2. Effect of Strain DJW5-2-1 on Various Pathogenic Fungi
3.3. Identification of Strain DJW5-2-1
3.3.1. Morphological Identification
3.3.2. Phylogenetic Tree Construction
3.4. Determination of Cell Wall-Degrading Enzymes Produced by Strain DJW5-2-1
3.5. Biocontrol Efficacy of Strain DJW5-2-1
3.6. Plant Growth-Promoting Ability of Strain DJW5-2-1
3.6.1. Determination of Plant Growth-Promoting Functions of Strain DJW5-2-1
3.6.2. Growth-Promoting Effect of Strain DJW5-2-1 on Rhododendron Seedlings
3.7. Induced Resistance of Strain DJW5-2-1 in Rhododendron Seedlings
4. Discussion
5. Conclusions
Supplementary Materials
Author Contributions
Funding
Institutional Review Board Statement
Informed Consent Statement
Data Availability Statement
Conflicts of Interest
References
- Xu, J.; Luo, H.; Nie, S.; Zhang, R.G.; Mao, J.F. The complete mitochondrial and plastid genomes of Rhododendron simsii, an important parent of widely cultivated azaleas. Mitochondrial DNA B 2021, 6, 1197–1199. [Google Scholar] [CrossRef]
- Cun, H.C.; He, P.B.; He, P.F.; Wu, Y.X.; Shahzad, M.; Tang, Z.X.; He, Y.Q. Etiological study on brown spot disease of alpine Rhododendron. J. Mycol. 2023, 42, 707–718. [Google Scholar] [CrossRef]
- Kowalik, M. Fungi and fungi-like Oomycetes isolated from affected leaves of rhododendron. Acta Mycol. 2008, 43, 21–27. [Google Scholar] [CrossRef]
- Shi, X.; Wang, Y.; Gong, S.; Liu, X.; Tang, M.; Tang, J.; Zhang, X. The preliminary analysis of flavonoids in the petals of Rhododendron delavayi, Rhododendron agastum and Rhododendron irroratum Infected with Neopestalotiopsis clavispora. Int. J. Mol. Sci. 2024, 25, 9605. [Google Scholar] [CrossRef]
- Gu, C.; Cheng, T.; Cai, N.; Li, W.; Zhang, G.; Zhou, X.G.; Zhang, D. Assessing narrow brown leaf spot severity and fungicide efficacy in rice using low altitude UAV imaging. Ecol. Inform. 2023, 77, 102208. [Google Scholar] [CrossRef]
- Cruz, C.D.; Mills, D.; Paul, P.A.; Dorrance, A.E. Impact of brown spot caused by Septoria glycines on soybean in Ohio. Plant Dis. 2010, 94, 820–826. [Google Scholar] [CrossRef]
- Hou, Y.; Ma, X.; Wan, W.; Long, N.; Zhang, J.; Tan, Y.; Dong, Y. Comparative genomics of pathogens causing brown spot disease of tobacco: Alternaria longipes and Alternaria alternata. PLoS ONE 2016, 11, e0155258. [Google Scholar] [CrossRef]
- Oliveira, L.F.; Feijó, F.M.; Mendes, A.L.; Neto, J.D.; Netto, M.S.; Assunção, I.P.; Lima, G.S. Identification of Colletotrichum species associated with brown spot of cactus prickly pear in Brazil. Trop. Plant Pathol. 2018, 43, 247–253. [Google Scholar] [CrossRef]
- Patsa, R.; Jash, S.; Dutta, S.; Barman, A.R.; Poduval, M.; Ray, S.K. Pestalotiopsis leaf spot: An important foliar disease in cashewnut seedling incited by Pestalotiopsis oxyanthi in West Bengal, India. Indian Phytopathol. 2023, 76, 713–725. [Google Scholar] [CrossRef]
- Park, J.; Kim, S.; Jo, M.; An, S.; Kim, Y.; Yoon, J. Isolation and identification of Alternaria alternata from potato plants affected by leaf spot disease in Korea: Selection of effective fungicides. J. Fungi 2024, 10, 53. [Google Scholar] [CrossRef] [PubMed]
- Imran, M.; Sahi, S.T.; Atiq, M.; Rasul, A. Brown leaf spot: An exacerbated embryonic disease of rice: A review. J. Innov. Sci. 2020, 6, 108–125. [Google Scholar] [CrossRef]
- Bhatnagar, S.; Kumari, R.; Kaur, I. Seaweed and a biocontrol agent and their effects on the growth and production of Brassica juncea: A sustainable approach. World J. Microb. Biotechnol. 2024, 40, 16. [Google Scholar] [CrossRef]
- Zhou, Y.T.; Wang, F.; Ying, J.B.; Liu, L.; Zhang, D.H.; Hong, Y.T.; Shen, D.Z. Identification and screening of the antagonistic endophytic Bacillus 6715 against anthracnose in Camellia oleifera in Dehongzhou. J. West China For. Sci. 2021, 50, 131–138. [Google Scholar]
- Meng, J.X.; Zhang, X.Y.; Han, X.S.; Fan, B. Application and development of biocontrol agents in China. Pathogens 2022, 11, 1120. [Google Scholar] [CrossRef] [PubMed]
- Gupta, S.; Chaturvedi, P.; Kulkarni, M.G.; Van Staden, J. A critical review on exploiting the pharmaceutical potential of plant endophytic Fungi. Biotechnol. Adv. 2020, 39, 107462. [Google Scholar] [CrossRef] [PubMed]
- Tejesvi, M.V.; Kajula, M.; Mattila, S.; Pirttilä, A.M. Bioactivity and genetic diversity of endophytic fungi in Rhododendron tomentosum Harmaja. Fungal Divers 2011, 47, 97–107. [Google Scholar] [CrossRef]
- Lin, L.C.; Ye, Y.S.; Lin, W.R. Characteristics of root-cultivable endophytic fungi from Rhododendron ovatum Planch. Braz. J. Microbiol. 2019, 50, 185–193. [Google Scholar] [CrossRef]
- Gu, R.; Bao, D.F.; Shen, H.W.; Su, X.J.; Li, Y.X.; Luo, Z.L. Endophytic Pestalotiopsis species associated with Rhododendron in cangshan mountain, Yunnan province, China. Front. Microbiol. 2022, 13, 1016782. [Google Scholar] [CrossRef]
- Zhang, C.; Yin, L.; Dai, S. Diversity of root-associated fungal endophytes in Rhododendron fortunei in subtropical forests of China. Mycorrhiza 2009, 1, 417–423. [Google Scholar] [CrossRef]
- Wang, S.J.; Chang, Z.H.; Zhang, Y.J. Analysis on the community composition and diversity of endophytic fungi in four species of Rhododendron in Tibet. Anhui Agric. Sci. 2023, 51, 138–143. [Google Scholar]
- Abramczyk, B.; Marzec-Grządzielewska, A.; Grządzielewski, J.; Król, E.; Gałązka, A. Biocontrol potential and catabolic profile of endophytic Diaporthe eres Strain 1420S from Prunus domestica L. in Poland—A Preliminary Study. Agronomy 2022, 12, 165. [Google Scholar] [CrossRef]
- Yehia, H.M.; Salmen, S.H.; Alharbi, S.A.; Khiyami, M.A.; Wainwright, M.; Alharbi, N.S. Antifungal protein (35 kDa) produced by Bacillus cereus inhibits the growth of some molds and yeasts. J. Pure Appl. Microbiol. 2013, 7, 401–406. [Google Scholar]
- Segaran, G.; Sathiavelu, M. Fungicidal and plant growthpromoting traits of Lasiodiplodia pseudotheobromae, an endophyte from Andrographis paniculata. Front. Plant Sci. 2023, 14, 1125630. [Google Scholar] [CrossRef]
- Gong, W.K.; Wu, Q.H.; Wang, G.; Yang, J.M.; Lu, R.T.; Wang, B.B. Screening of microorganisms promoting rhizosphere growth in dragon fruit. J. Trop. Biol. 2024, 15, 632–638. [Google Scholar] [CrossRef]
- Guo, X.L.; Wang, Y.Q.; Hu, J.B.; Wang, D.L.; Wang, J.B.; Shakeel, M. Mixed inoculation of dark septate endophytic and ericoid mycorrhizal fungi in different proportions improves the growth and nutrient content of blueberry seedlings. Plant Biosyst. 2023, 157, 497–506. [Google Scholar] [CrossRef]
- Zhang, L.H.; Xu, W.; Zhao, Z.B.; Long, Y.H.; Fan, R. Biocontrol potential and growth—Promoting effect of endophytic fungus Talaromyces muroii SD1-4 against potato leaf spot disease caused by Alternaria alternata. BMC Microbiol. 2024, 24, 255. [Google Scholar] [CrossRef]
- Akram, S.; Ahmed, A.; He, P.F.; He, P.B.; Liu, Y.L.; Wu, Y.X.; Munir, S.; He, Y.Q. Uniting the role of endophytic fungi against plant pathogens and their interaction. J. Fungi 2023, 9, 72. [Google Scholar] [CrossRef]
- Li, H.; Yang, M.; Liu, J.; Sun, Y.; Yang, H.; Lu, J. Isolation and identification of antagonistic fungi for biocontrol of Impatiens hawkeri leaf spot disease and their growth-promoting potential. Front. Microbiol. 2025, 16, 1584353. [Google Scholar] [CrossRef]
- Li, Q.S.; Xie, Y.C.; Rahman, M.M.; Hashem, A.; Abd_Allah, E.F.; Wu, Q.S. Arbuscular mycorrhizal Fungi and Endophytic Fungi Activate Leaf Antioxidant Defense System of Lane Late Navel Orange. J. Fungi 2022, 8, 282. [Google Scholar] [CrossRef]
- Zou, Y.; Zhang, L.; Liu, R.; He, L.; Hu, Z.; Liang, Y.; Lin, F.; Zhou, Y. Endophytic fungus Falciphora oryzae enhances salt tolerance by modulating ion homeostasis and antioxidant defense systems in pepper. Physiol. Plant. 2023, 175, e14059. [Google Scholar] [CrossRef] [PubMed]
- Nazir, K.; Hafeez, F. Bioactive potentials of endophyte (Fusarium redolens) isolated from Olea europaea. Arch. Microbiol. 2022, 204, 219. [Google Scholar] [CrossRef]
- Marwa, M.G.; Heba, I.M.; Ahmed, A.A.O. The antagonistic activity of certain fungal endophytes against some phytopathogenic fungi through their metabolites and extracellular enzymes. Phytoprotection 2021, 101, 7–16. [Google Scholar] [CrossRef]
- Su, Y.Y.; Qi, Y.L.; Cai, L. Induction of sporulation in plant pathogenic fungi. Mycology 2012, 3, 195–200. [Google Scholar] [CrossRef]
- Chen, J.; Xu, L.L.; Liu, B.; Liu, X.Z. Taxonomy of Dactylella complex and Vermispora.I. Generic concepts based on morphology and ITS sequences data. Fungal Divers 2007, 26, 73–83. [Google Scholar]
- White, T.J.; Bruns, T.; Lee, S.; Taylor, J. Amplification and direct sequencing of fungal ribosomal RNA genes for 783 phylogenetics. PCR Protoc. Guide. Methods Appl. 1990, 18, 315–322. [Google Scholar]
- Carbone, I.; Kohn, L.M. A method for designing primer sets for speciation studies in filamentous ascomycetes. Mycologia 1999, 91, 553–556. [Google Scholar] [CrossRef]
- Glass, N.L.; Donaldson, G.C. Development of primer sets designed for use with the PCR to amplify conserved genes from filamentous ascomycetes. Appl. Environ. Microb. 1995, 61, 1323–1330. [Google Scholar] [CrossRef] [PubMed]
- Sopalun, K.; Iamtham, S. Isolation and screening of extracellular enzymatic activity of endophytic fungi isolated from Thai orchids. S. Afr. J. Bot. 2020, 134, 273–279. [Google Scholar] [CrossRef]
- Mwendwa, P.K.; Omwenga, G.I.; Maingi, J.M.; Karanja, A.W. Evaluation of cellulase production by endophytic fungi isolated from young and mature leaves of medicinal plants using maize cob substrate. Sci. Rep. 2025, 15, 17842. [Google Scholar] [CrossRef] [PubMed]
- El-Shora, H.M.; El-Sharkawy, R.M.; Khateb, A.M.; Darwish, D.B. Production and immobilization of β-glucanase from Aspergillus niger with its applications in bioethanol production and biocontrol of phytopathogenic fungi. Sci. Rep. 2021, 11, 21000. [Google Scholar] [CrossRef]
- Malik, M.S.; Haider, S.; Rehman, A.; Rehman, S.U.; Jamil, M.; Naz, I.; Anees, M. Biological control of fungal pathogens of tomato (Lycopersicon esculentum) by chitinolytic bacterial strains. J. Basic Microb. 2022, 62, 48–62. [Google Scholar] [CrossRef]
- Sun, Y.; Tian, Y.; Liu, J.; Li, H.; Lu, J.; Wang, M.; Liu, S. Isolation and identification of Colletotrichum nymphaeae as a causal agent of leaf spot on Rhododendron hybridum Ker Gawl and its effects on the ultrastructure of host plants. J. Fungi 2025, 11, 392. [Google Scholar] [CrossRef] [PubMed]
- Wang, Q.; Zhang, X.; Xie, Q.; Tao, J.; Jia, Y.; Xiao, Y.; Bu, T. Exploring plant growth-promoting traits of endophytic fungi isolated from ligusticum chuanxiong hort and their interaction in plant growth and development. J. Fungi 2024, 10, 713. [Google Scholar] [CrossRef]
- Abdelhamid, S.A.; Abo Elsoud, M.M.; El-Baz, A.F.; Nofal, A.M.; El-Banna, H.Y. Optimisation of indole acetic acid production by Neopestalotiopsis aotearoa endophyte isolated from Thymus vulgaris and its impact on seed germination of Ocimum basilicum. BMC Biotechnol. 2024, 24, 46. [Google Scholar] [CrossRef] [PubMed]
- Hartmut, K.; Alan, R.W. Determinations of total carotenoids and chlorophylls b of leaf extracts in different solvents. Analysis 1983, 4, 142–196. [Google Scholar]
- Wu, M.; Jiang, W.; Lu, C.; Dong, W.; Fan, J.; Tian, J.; He, Y. Effect of defense enzyme activities, endogenous SA and MeSA in tea plants on the host adaptability of Toxoptera aurantii (Hemiptera: Aphididae). Crop Prot. 2025, 190, 107135. [Google Scholar] [CrossRef]
- Shen, Z.; Luo, Q.; Mao, J.; Li, Y.; Wang, M.; Zhang, L. Molecular identification of two thioredoxin genes and their function in antioxidant defense in Arma chinensis diapause. Front. Physiol. 2024, 15, 1440531. [Google Scholar] [CrossRef]
- Cha, J.E.; Eo, J.K.; Eom, A.H. Four unrecorded species of endophytic Diaporthe (Sordariomycetes) in Korea. Mycobiology 2024, 52, 477–485. [Google Scholar] [CrossRef]
- Hilário, S.; Gonçalves, M.F.M. Mechanisms Underlying the pathogenic and endophytic lifestyles in Diaporthe: An Omics-based approach. Horticulturae 2023, 9, 423. [Google Scholar] [CrossRef]
- Zhang, Y.D.; Manawasinghe, I.S.; Huang, Y.H.; Shu, Y.X.; Phillips, A.J.L.; Dissanayake, A.J.; Hyde, K.D.; Xiang, M.M.; Luo, M. Endophytic Diaporthe associated with citrus grandis cv. tomentosa in China. Front. Microbiol. 2021, 11, 609387. [Google Scholar] [CrossRef] [PubMed]
- Lambert, C.; Schweizer, L.; Matio Kem Ku Ignou, B.; Anoumedem, E.G.M.; Kouam, S.F.; Marin-Felix, Y. Four new endophytic species of Diaporthe (Diaporthaceae, Diaporthales) isolated from Cameroon. MycoKeys 2023, 99, 319–362. [Google Scholar] [CrossRef]
- Toghueo, R.M.K.; Tchameni, E.; Simo, G.F.; Nkeng, C.A.; Ndoumbe-Nkeng, S.; Nguefack, J. A Diaporthe fungal endophyte from a wild grass improves growth and salinity tolerance of tritordeum and perennial ryegrass. Front. Plant Sci. 2022, 13, 896755. [Google Scholar] [CrossRef]
- Niaz, S.I.; Khan, D.F.; Naz, R.; Safdar, K.; Abidin, S.Z.U.; Khan, I.U.; Gul, R.; Khan, W.U.; Khan, M.A.U.; Lan, L. Antimicrobial and antioxidant chlorinated azaphilones from mangrove Diaporthe perseae sp. isolated from the stem of Chinese mangrove Pongamia pinnata. J. Asian Nat. Prod. Res. 2020, 23, 1077–1084. [Google Scholar] [CrossRef]
- Yan, D.H.; Song, X.; Li, H.; Luo, T.; Dou, G.; Strobel, G. Antifungal activities of volatile secondary metabolites of four Diaporthe strains isolated from Catharanthus roseus. J. Fungi 2018, 4, 65. [Google Scholar] [CrossRef]
- Kapoora, N.; Ntemafack, A.; Chouhan, R.; Gandhi, S.G. Anti-phytopathogenic and plant growth promoting potential of endophytic fungi isolated from Dysoxylum gotadhora. Arch. Phytopathol. Plant Prot. 2022, 55, 454–473. [Google Scholar] [CrossRef]
- Chamier, A.C. Cell-wall-degrading enzymes of aquatic hyphomycetes: A review. Bot. J. Linn. Soc. 1985, 91, 67–81. [Google Scholar] [CrossRef]
- Yuan, Y.; Feng, H.; Wang, L.; Li, Z.; Shi, Y.; Zhao, L.; Zhu, H. Potential of endophytic fungi isolated from cotton roots for biological control against verticillium wilt disease. PLoS ONE 2017, 12, e0170557. [Google Scholar] [CrossRef]
- da Silva Santos, S.; de Oliveira, J.A.S.S.; Brandão Filho, J.U.T.; Azevedo, J.L.; Pamplile, J.A. Influence of plant growth-promoting endophytes Colletotrichum siamense and Diaporthe masirevicii on tomato plants. J. Fungi 2022, 8, 522. [Google Scholar] [CrossRef]
- Castelli, M.V.; Ruiz Mostacero, N.; Fulgueira, C.L.; López, S.N. The Genus Diaporthe: A Prolific source of novel bioactive metabolites. In The Book of Fungal Pathogens; Nova Science Publishers: New York, NY, USA, 2020; pp. 215–245. [Google Scholar]
- Apel, K.; Hirt, H. Reactive oxygen species in plant–pathogen interactions. Annu. Rev. Plant Biol. 2004, 55, 373–399. [Google Scholar] [CrossRef]
- Hafiz, F.B.; Moradtalab, N.; Goertz, S.; Rietz, S.; Dietel, K.; Rozhon, W.; Humbeck, K.; Geistlinger, J.; Neumann, G.; Schellenberg, I. Synergistic effects of a root-endophytic Trichoderma Fungus and Bacillus on early root colonization and defense activation against Verticillium longisporum in Rapeseed. Mol. Plant-Microbe Interact. 2022, 35, 380–392. [Google Scholar] [CrossRef]
- Khan, A.; Li, B.; Zhang, C. Bipolaris sp. CSL-1 induces salt tolerance in Glycine maxvia modulating antioxidative system. Plant Signal Behav. 2022, 17, e2036836. [Google Scholar] [CrossRef]
- Farouk, H.M.; Attia, E.Z.; Shaban, G.M.; Abdelmohsen, U.R.; El-Katatny, M.H. Antimicrobial secondary metabolites and antioxidant activities of fungal endophytes associated with Ziziphus spina-christi (L.) Desf. (Nabq) leaves. Nat. Prod. Res. 2024, 39, 4788–4792. [Google Scholar] [CrossRef] [PubMed]
- Savani, A.K.; Bhattacharyya, A.; Baruah, A. Endophyte mediated activation of defense enzymes in banana plants pre-immunized with covert endophytes. Indian Phytopathol. 2020, 73, 433–441. [Google Scholar] [CrossRef]
- Sonia, W.Q.; Adil, A.B.; Abrar, A.K. Endophytic fungi: Unravelling plant-endophyte interaction and the multifaceted role of fungal endophytes in stress amelioration. Plant Physiol. Biochem. 2024, 206, 108174. [Google Scholar] [CrossRef]

| Strains | XY-4 | |
|---|---|---|
| Colony Diameter (mm) | Inhibition Rate (%) | |
| CK | 81.82 ± 0.23 a | |
| DJY1-1 | 39.79 ± 1.85 b | 51.36 ± 2.26 c |
| DJW5-2 | 38.25 ± 0.76 b | 53.24 ± 0.93 c |
| DJW5-2-1 | 29.56 ± 1.25 d | 63.88 ± 1.53 a |
| DJW5-3 | 34.6 ± 1.16 b | 57.72 ± 1.42 b |
| DJW5-4 | 32.97 ± 1.39 c | 59.70 ± 1.70 b |
| Strain | Species Latin Name | Accession Number | ||
|---|---|---|---|---|
| ITS | TEF | TUB | ||
| DJW5-2-1 | Diaporthe phoenicicola | PV915598 | PV948861 | PV948860 |
| MFLUCC 24-0368 | Diaporthe phoenicicola | PQ699356.1 | PQ659935.1 | PQ659927.1 |
| MFLUCC:24-0367 | Diaporthe phoenicicola | PQ699364.1 | PQ659937.1 | PQ659930.1 |
| MFLUCC:24-0366 | Diaporthe phoenicicola | PQ699363.1 | PQ659933.1 | PQ659925.1 |
| CBS 111811 | Diaporthe amygdali | KC343019 | KC343745 | KC343987 |
| CBS 126680 | Diaporthe amygdali | KC343023 | KC343749 | KC343991 |
| CFCC 52586 | Diaporthe kadsurae | MH121521 | MH121563 | MH121600 |
| CFCC 52587 | Diaporthe kadsurae | MH121522 | MH121564 | MH121601 |
| CFCC 50469 | Diaporthe betulae | KT732950 | KT733016 | KT733020 |
| CBS 462.69 | Diaporthe pseudohoenicicola | KC343184 | KC343910 | KC344152 |
| CBS 176.77 | Diaporthe pseudohoenicicola | KC343183 | KC343909 | KC344151 |
| MFLU 18-2599 | Diaporthe pseudohoenicicola | MW114352.1 | MW192215.1 | MW148272.1 |
| NCYU 19-0024 | Diaporthe pseudohoenicicola | MW114353.1 | MW192216.1 | MW148273.1 |
| CBS 186.37 | Diaporthe eres | MH867392.1 | KC343810.1 | KC344047.1 |
| CBS 102.81 | Diaporthe eres | KC343074.1 | KC343800.1 | KC344042.1 |
| CBS 160.32 | Diaporthe vaccinii | KC343228 | KC343954 | KC344196 |
| CBS 114015 | Diaporthe ambigua | KC343010 | KC343736 | KC343978 |
| CBS 117167 | Diaporthe ambigua | KC343011 | KC343737 | KC343979 |
| CBS 161.64 | Diaporthe arecae | KC343032 | KC343758 | KC344000 |
| MFLUCC 24-0427 | Diaporthe arecae | PQ699352.1 | PV768975.1 | PV753770.1 |
| CBS 535.75 | Diaporthe arecae | KC343033 | KC343759 | KC344001 |
| CBS 127271 | Diaporthe novem | MH864504.1 | KC343883.1 | KC344125 |
| CBS127270 | Diaporthe novem | MH864503.1 | KC343641.1 | KC344124.1 |
| CBS 121124 | Diaporthella corylina | KC343004 | KC343730 | KC343972 |
| In Vitro Biocontrol Efficacy | Potted Plant Biocontrol Efficacy | |||
|---|---|---|---|---|
| Disease Index | Biocontrol Efficacy (%) | Disease Index | Biocontrol Efficacy (%) | |
| CK | 79.63 ± 5.23 a | 37.17 ± 2.46 a | ||
| DJW5-2-1 | 40.37 ± 7.11 b | 49.67 ± 5.97 | 18.33 ± 1.18 b | 50.61 ± 2.01 |
| Growth Indices | CK | DJW5-2-1 | Growth-Promoting Efficiency/% |
|---|---|---|---|
| plant height/cm | 20.3 ± 1.28 b | 23.4 ± 1.68 a | 15.27 |
| root length/cm | 4.95 ± 0.73 b | 5.62 ± 0.75 ab | 13.53 |
| stem diameter/cm | 0.24 ± 0.04 b | 0.34 ± 0.04 a | 41.27 |
| leaf area/cm2 | 2.35 ± 0.38 b | 3.16 ± 0.64 a | 34.47 |
| chlorophyll content mg/g | 2.21 ± 0.05 b | 3.44 ± 0.07 a | 55.66 |
| aboveground fresh weight/g | 1.30 ± 0.07 b | 2.37 ± 0.24 a | 82.31 |
| aboveground dry weight/g | 0.57 ± 0.06 b | 1.11 ± 0.08 a | 94.73 |
| root fresh weight/g | 0.32 ± 0.06 b | 1.15 ± 0.04 a | 259.37 |
| root dry weight/g | 0.14 ± 0.005 b | 0.40 ± 0.03 a | 185.71 |
Disclaimer/Publisher’s Note: The statements, opinions and data contained in all publications are solely those of the individual author(s) and contributor(s) and not of MDPI and/or the editor(s). MDPI and/or the editor(s) disclaim responsibility for any injury to people or property resulting from any ideas, methods, instructions or products referred to in the content. |
© 2025 by the authors. Licensee MDPI, Basel, Switzerland. This article is an open access article distributed under the terms and conditions of the Creative Commons Attribution (CC BY) license (https://creativecommons.org/licenses/by/4.0/).
Share and Cite
Sun, Y.; Liu, J.; Li, H.; Zhu, G.; Zhu, C.; Lu, J.; Ma, Y. Identification of the Antagonistic Fungus Diaporthe phoenicicola Against Rhododendron Brown Spot Disease and Its Disease Control and Plant Growth-Promoting Efficacy. J. Fungi 2025, 11, 728. https://doi.org/10.3390/jof11100728
Sun Y, Liu J, Li H, Zhu G, Zhu C, Lu J, Ma Y. Identification of the Antagonistic Fungus Diaporthe phoenicicola Against Rhododendron Brown Spot Disease and Its Disease Control and Plant Growth-Promoting Efficacy. Journal of Fungi. 2025; 11(10):728. https://doi.org/10.3390/jof11100728
Chicago/Turabian StyleSun, Yajiao, Jian Liu, Huali Li, Guangyao Zhu, Chengfen Zhu, Junjia Lu, and Yunqiang Ma. 2025. "Identification of the Antagonistic Fungus Diaporthe phoenicicola Against Rhododendron Brown Spot Disease and Its Disease Control and Plant Growth-Promoting Efficacy" Journal of Fungi 11, no. 10: 728. https://doi.org/10.3390/jof11100728
APA StyleSun, Y., Liu, J., Li, H., Zhu, G., Zhu, C., Lu, J., & Ma, Y. (2025). Identification of the Antagonistic Fungus Diaporthe phoenicicola Against Rhododendron Brown Spot Disease and Its Disease Control and Plant Growth-Promoting Efficacy. Journal of Fungi, 11(10), 728. https://doi.org/10.3390/jof11100728

